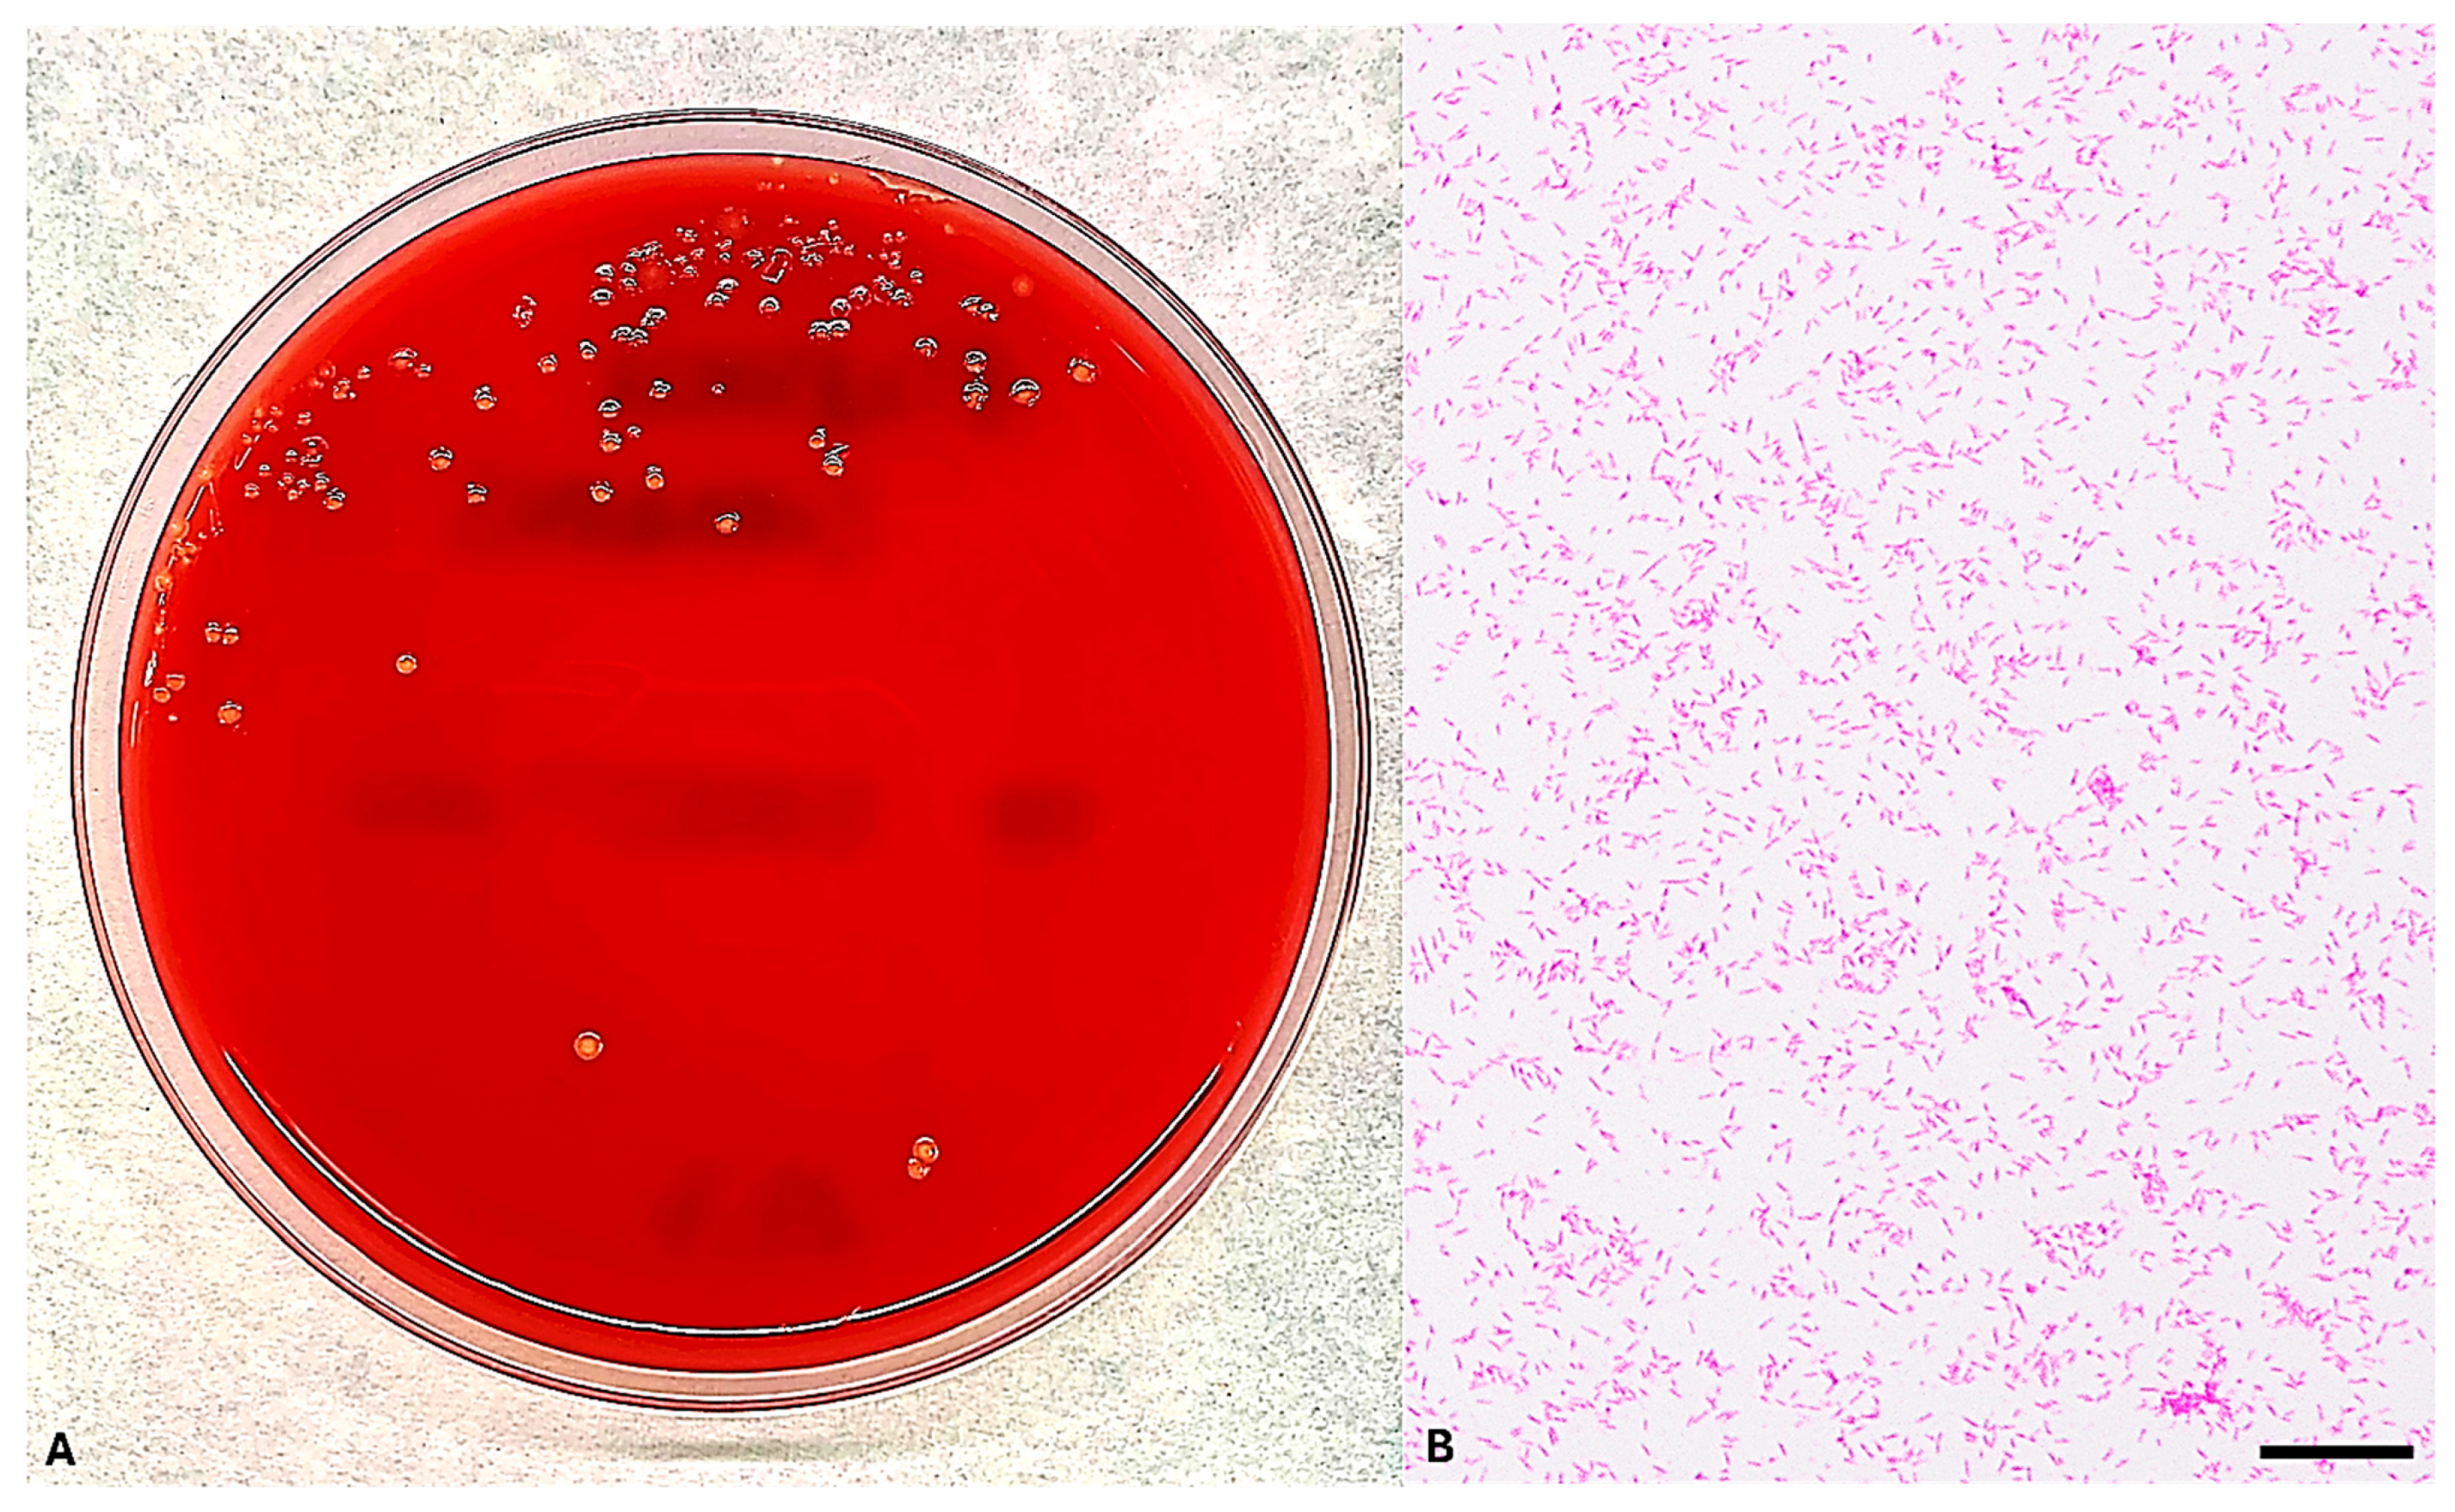
Microorganisms 13 02135 g002 Microorganisms 13 02135 g002

Crossing the Barrier: Eikenella corrodens Bacteremia Following CNS Infection in a Patient Treated with Nivolumab—A Case Report and Literature Review
Abstract
1. Introduction
2. Case Report
3. Materials and Methods
3.1. Microbiological Culture and Microscopy
3.2. MALDI-TOF MS Identification of E. corrodens
3.3. Molecular Confirmation of E. corrodens Identification
3.4. Antimicrobial Susceptibility Testing of E. corrodens
3.5. Study Research and Inclusion Strategies
4. Results
4.1. Blood Culture Isolation and Microscopic Examination of E. corrodens
4.2. MALDI-TOF MS-Based Identification of E. corrodens
4.3. Sequencing-Based Identification of E. corrodens
4.4. MIC Results of E. corrodens
4.5. Literature Review of E. corrodens Secondary Bacteremia
5. Discussion
6. Conclusions
Supplementary Materials
Author Contributions
Funding
Institutional Review Board Statement
Informed Consent Statement
Data Availability Statement
Conflicts of Interest
Abbreviations
| BSI | Bloodstream infection |
| CLSI | Clinical & Laboratory Standards Institute |
| CTLA-4 | Cytotoxic T-Lymphocyte Antigen 4 |
| CVC | Central venous catheter |
| EUCAST | European Committee on Antimicrobial Susceptibility Testing |
| HACEK | Haemophilus species, Aggregatibacter actinomycetemcomitans, Cardiobacterium hominis, Eikenella corrodens, Kingella kingae |
| HIV | Human immunodeficiency viruses |
| ICI | Immune checkpoint inhibitor |
| IgG | Immunoglobulin G |
| irAEs | Immune-related adverse events |
| MALDI-TOF MS | Matrix-Assisted Laser Desorption/Ionization Time-of-Flight Mass Spectrometry |
| MIC | Minimum Inhibitory Concentration |
| NCBI | National Center for Biotechnology Information |
| PCR | Polymerase chain reaction |
| PD-1 | Programmed Cell Death Protein 1 |
| rRNA | Ribosomal ribonucleic acid |
References
- Gajurel, B.P.; Giri, S.; Rayamajhi, S.; Khanal, N.; Bishowkarma, S.; Mishra, A.; Karn, R.; Rajbhandari, R.; Ojha, R. Epidemiological and Clinical Characteristics of Central Nervous System Infections in a Tertiary Center: A Retrospective Study. Health Sci. Rep. 2023, 6, e1099. [Google Scholar] [CrossRef]
- Zimmer, A.J.; Burke, V.E.; Bloch, K.C. Central Nervous System Infections. Microbiol. Spectr. 2016, 4, 629–651. [Google Scholar] [CrossRef]
- Archibald, L.K.; Quisling, R.G. Central Nervous System Infections. In Textbook of Neurointensive Care; Springer: Berlin/Heidelberg, Germany, 2013; pp. 427–517. [Google Scholar] [CrossRef]
- Brook, I. Microbiology and Management of Deep Facial Infections and Lemierre Syndrome. ORL 2003, 65, 117–120. [Google Scholar] [CrossRef]
- Hu, C.-Y.; Lien, K.-H.; Chen, S.-L.; Chan, K.-C. Risk Factors of Descending Necrotizing Mediastinitis in Deep Neck Abscesses. Medicina 2022, 58, 1758. [Google Scholar] [CrossRef]
- Bandol, G.; Cobzeanu, M.D.; Moscalu, M.; Palade, O.D.; Moisii, L.; Severin, F.; Patrascanu, E.; Mocanu, F.; Roman, A.I.; Cobzeanu, B.M. Deep Neck Infections: The Effectiveness of Therapeutic Management and Bacteriological Profile. Medicina 2025, 61, 129. [Google Scholar] [CrossRef] [PubMed]
- Zhou, X.; Wu, Y.; Zhu, Z.; Lu, C.; Zhang, C.; Zeng, L.; Xie, F.; Zhang, L.; Zhou, F. Mucosal Immune Response in Biology, Disease Prevention and Treatment. Signal Transduct. Target. Ther. 2025, 10, 7. [Google Scholar] [CrossRef] [PubMed]
- Patel, K.; Clifford, D.B. Bacterial Brain Abscess. Neurohospitalist 2014, 4, 196–204. [Google Scholar] [CrossRef] [PubMed]
- Maniglia, A.J.; Goodwin, W.J.; Arnold, J.E.; Ganz, E. Intracranial Abscesses Secondary to Nasal, Sinus, and Orbital Infections in Adults and Children. Arch. Otolaryngol. Head Neck Surg. 1989, 115, 1424–1429. [Google Scholar] [CrossRef]
- Bodilsen, J.; Mariager, T.; Larsen, L.; Brandt, C.T.; Hansen, B.R.; Wiese, L.; Omland, L.H.; Nielsen, H.; Storgaard, M.; Larsen, L.; et al. Brain Abscess Caused by Oral Cavity Bacteria: A Nationwide, Population-Based Cohort Study. Clin. Infect. Dis. 2023, 78, 544–553. [Google Scholar] [CrossRef]
- Nguyen, I.; Urbanczyk, K.; Mtui, E.; Li, S. Intracranial CNS Infections: A Literature Review and Radiology Case Studies. Semin. Ultrasound CT MRI 2020, 41, 106–120. [Google Scholar] [CrossRef]
- Rogacheva, Y.; Popova, M.; Lepik, K.; Kondakova, E.; Zalyalov, Y.; Stelmakh, L.; Volkova, A.; Nikolaev, I.; Goloshchapov, O.; Barhatov, I.; et al. PS1282 Infectious Complications of Nivolumab Therapy in Relapsed/Refractory Hodgkin’s Lymphoma. HemaSphere 2019, 3, 587. [Google Scholar] [CrossRef]
- Ross, J.A.; Komoda, K.; Pal, S.; Dickter, J.; Salgia, R.; Dadwal, S. Infectious Complications of Immune Checkpoint Inhibitors in Solid Organ Malignancies. Cancer Medicine 2021, 11, 21–27. [Google Scholar] [CrossRef]
- Ocaña-Guzmán, R.; Osorio-Pérez, D.; Chávez-Galán, L. Opportunistic Infections and Immune-Related Adverse Events Associated with Administering Immune Checkpoint Inhibitors: A Narrative Review. Pharmaceuticals 2023, 16, 1119. [Google Scholar] [CrossRef]
- Tezuka, T.; Takahashi, N.; Tokuyasu, D.; Azami, S.; Sekiguchi, K.; Takizawa, T.; Izawa, Y.; Nakahara, J.; Katsumata, M. Cerebral Venous Thrombosis Mimicking Limbic Encephalitis. Intern. Med. 2024, 63, 1277–1280. [Google Scholar] [CrossRef]
- Li, L.; Shi, Y.; Weng, X. Eikenella corrodens Infections in Human: Reports of Six Cases and Review of Literatures. J. Clin. Lab. Anal. 2022, 36, e24230. [Google Scholar] [CrossRef]
- Emmerson, A.M.; Mills, F. Recurrent Meningitis and Brain Abscess Caused by Eikenella corrodens. Postgrad. Med. J. 1978, 54, 343–345. [Google Scholar] [CrossRef]
- Zgheib, A.; el Allaf, D.; Demonty, J.; Rorive, G. Intrathoracic Infections with Bacteraemia due to Eikenella corrodens as a Complication of Peritonsillar Abscesses: Report of a Case and Review of the Literature. Acta Clin. Belg. 1992, 47, 124–128. [Google Scholar] [CrossRef]
- Dong, X.-Y.; Gong, L. Chronic Meningitis Caused by Eikenella corrodens. Kaohsiung J. Med. Sci. 2013, 29, 466–467. [Google Scholar] [CrossRef] [PubMed]
- Sawyer, C.; Angelis, D.; Bennett, R. Eikenella corrodens Sepsis with Cerebrospinal Fluid Pleocytosis in a Very Low Birth Weight Neonate. Case Rep. Pediatr. 2015, 2015, 686812. [Google Scholar] [CrossRef] [PubMed]
- Yamagishi, T.; Hikone, M.; Sugiyama, K.; Tanabe, T.; Wada, Y.; Furugaito, M.; Arai, Y.; Uzawa, Y.; Mizushima, R.; Kamada, K.; et al. Purpura Fulminans with Lemierre’s Syndrome Caused by Gemella bergeri and Eikenella corrodens: A Case Report. BMC Infect. Dis. 2018, 18, 523. [Google Scholar] [CrossRef] [PubMed]
- Berge, A.; Morenius, C.; Petropoulos, A.; Nilson, B.; Rasmussen, M. Epidemiology, Bacteriology, and Clinical Characteristics of HACEK Bacteremia and Endocarditis: A Population-Based Retrospective Study. Eur. J. Clin. Microbiol. Infect. Dis. 2020, 40, 525–534. [Google Scholar] [CrossRef]
- Rodríguez-Rojas, L.; Suarez-López, A.; Cantón, R.; Ruiz-Garbajosa, P. Eikenella corrodens Causing Deep-Seated Infections. Six-Year Experience in a University Hospital in Madrid. Enfermedades Infecc. Y Microbiol. Clínica 2020, 38, 76–78. [Google Scholar] [CrossRef]
- Tobinick, E.; Vega, C.P. The Cerebrospinal Venous System: Anatomy, Physiology, and Clinical Implications. MedGenMed Medscape Gen. Med. 2006, 8, 53. [Google Scholar]
- Shiravand, Y.; Khodadadi, F.; Kashani, S.M.A.; Hosseini-Fard, S.R.; Hosseini, S.; Sadeghirad, H.; Ladwa, R.; O’Byrne, K.; Kulasinghe, A. Immune Checkpoint Inhibitors in Cancer Therapy. Curr. Oncol. 2022, 29, 3044–3060. [Google Scholar] [CrossRef]
- Petrelli, F.; Morelli, A.M.; Luciani, A.; Ghidini, A.; Solinas, C. Risk of Infection with Immune Checkpoint Inhibitors: A Systematic Review and Meta-Analysis. Target. Oncol. 2021, 16, 553–568. [Google Scholar] [CrossRef]
- Lombardi, A.; Saydere, A.; Ungaro, R.; Bozzi, G.; Viero, G.; Bandera, A.; Gori, A.; Mondelli, M.U. Infectious Events in Patients Treated with Immune Checkpoint Inhibitors, Chimeric Antigen Receptor T Cells, and Bispecific T-Cell Engagers: A Review of Registration Studies. Int. J. Infect. Dis. 2022, 120, 77–82. [Google Scholar] [CrossRef]
- Wang, X.; Wu, Y.; Hu, W.; Zhang, J. Incidence and Risk Factors of Serious Infections Occurred in Patients with Lung Cancer Following Immune Checkpoint Blockade Therapy. BMC Cancer 2025, 25, 307. [Google Scholar] [CrossRef]
- Cosio, T.; Coniglione, F.; Flaminio, V.; Gaziano, R.; Coletta, D.; Petruccelli, R.; Dika, E.; Bianchi, L.; Campione, E. Pyodermitis during Nivolumab Treatment for Non-Small Cell Lung Cancer: A Case Report and Review of the Literature. Int. J. Mol. Sci. 2023, 24, 4580. [Google Scholar] [CrossRef] [PubMed]
- Yin, Q.; Wu, L.; Han, L.; Xiao, Z.; Tong, R.; Lian, L.; Bai, L.; Bian, Y. Immune-Related Adverse Events of Immune Checkpoint Inhibitors: A Review. Front. Immunol. 2023, 14, 1167975. [Google Scholar] [CrossRef] [PubMed]
- Karam, J.-D.; Noel, N.; Voisin, A.-L.; Lanoy, E.; Michot, J.-M.; Lambotte, O. Infectious Complications in Patients Treated with Immune Checkpoint Inhibitors. Eur. J. Cancer 2020, 141, 137–142. [Google Scholar] [CrossRef] [PubMed]
- Mannavola, C.M.; De Maio, F.; Marra, J.; Fiori, B.; Santarelli, G.; Posteraro, B.; Sica, S.; D’Inzeo, T.; Sanguinetti, M. Bloodstream Infection by Lactobacillus Rhamnosus in a Haematology Patient: Why Metagenomics Can Make the Difference. Gut Pathog. 2025, 17, 47. [Google Scholar] [CrossRef]
- Rajasekaran, J.J.; Krishnamurthy, H.K.; Bosco, J.; Jayaraman, V.; Krishna, K.; Wang, T.; Bei, K. Oral Microbiome: A Review of Its Impact on Oral and Systemic Health. Microorganisms 2024, 12, 1797. [Google Scholar] [CrossRef] [PubMed]
- Verheijden, R.J.; van Eijs, M.V.M.; Paganelli, F.L.; Viveen, M.C.; Rogers, M.R.C.; Top, J.; May, A.M.; van de Wijgert, J.H.; Suijkerbuijk, K.P. Gut Microbiome and Immune Checkpoint Inhibitor Toxicity. Eur. J. Cancer 2025, 216, 115221. [Google Scholar] [CrossRef]
- Ray, K. Oral Microbiome Could Provide Clues to CRC. Nat. Rev. Gastroenterol. Hepatol. 2017, 14, 690. [Google Scholar] [CrossRef]
- Liu, J.; Xu, C.; Wang, R.; Huang, J.; Zhao, R.; Wang, R. Microbiota and Metabolomic Profiling Coupled with Machine Learning to Identify Biomarkers and Drug Targets in Nasopharyngeal Carcinoma. Front. Pharmacol. 2025, 16, 1551411. [Google Scholar] [CrossRef]
- Sheng, E.; Ong, Y.; Chou, Y.; Then, C.K. Interconnected Influences of Tumour and Host Microbiota on Treatment Response and Side Effects in Nasopharyngeal Cancer. Crit. Rev. Oncol. Hematol. 2024, 202, 104468. [Google Scholar] [CrossRef]
- Parahitiyawa, N.B.; Jin, L.J.; Leung, W.K.; Yam, W.C.; Samaranayake, L.P. Microbiology of Odontogenic Bacteremia: Beyond Endocarditis. Clin. Microbiol. Rev. 2009, 22, 46–64. [Google Scholar] [CrossRef] [PubMed]
- Castillo, D.M.; Sánchez-Beltrán, M.C.; Castellanos, J.E.; Sanz, I.; Mayorga-Fayad, I.; Sanz, M.; Lafaurie, G.I. Detection of Specific Periodontal Microorganisms from Bacteraemia Samples after Periodontal Therapy Using Molecular-Based Diagnostics. J. Clin. Periodontol. 2011, 38, 418–427. [Google Scholar] [CrossRef]
- Derosa, L.; Routy, B.; Desilets, A.; Daillère, R.; Terrisse, S.; Kroemer, G.; Zitvogel, L. Microbiota-Centered Interventions: The next Breakthrough in Immuno-Oncology? Cancer Discov. 2021, 11, 2396–2412. [Google Scholar] [CrossRef]
- Avni, T.; Leibovici, L.; Paul, M. PCR Diagnosis of Invasive Candidiasis: Systematic Review and Meta-Analysis. J. Clin. Microbiol. 2010, 49, 665–670. [Google Scholar] [CrossRef] [PubMed]
- Jordana-Lluch, E.; Giménez, M.; Quesada, M.D.; Ausina, V.; Martró, E. Improving the Diagnosis of Bloodstream Infections: PCR Coupled with Mass Spectrometry. BioMed Res. Int. 2014, 2014, 501214. [Google Scholar] [CrossRef] [PubMed]
- European Committee on Antimicrobial Susceptibility Testing. Guidance Document: What to Do When There Are No Breakpoints. Eucast. 2025. Available online: https://www.eucast.org/clinical_breakpoints_and_dosing/when_there_are_no_breakpoints (accessed on 28 August 2025).
- Luong, N.; Tsai, J.; Chen, C. Susceptibilities of Eikenella corrodens, Prevotella intermedia, and Prevotella nigrescens Clinical Isolates to Amoxicillin and Tetracycline. Antimicrob. Agents Chemother. 2001, 45, 3253–3255. [Google Scholar] [CrossRef]
- Nau, R.; Sorgel, F.; Eiffert, H. Penetration of Drugs through the Blood-Cerebrospinal Fluid/Blood-Brain Barrier for Treatment of Central Nervous System Infections. Clin. Microbiol. Rev. 2010, 23, 858–883. [Google Scholar] [CrossRef]
- Bodilsen, J.; D’Alessandris, Q.G.; Humphreys, H.; Iro, M.A.; Klein, M.; Last, K.; López-Montesinos, I.; Pagliano, P.; Sipahi, O.R.; Juan, R.S.; et al. ESCMID Guidelines on Diagnosis and Treatment of Brain Abscess in Children and Adults. Clin. Microbiol. Infect. 2023, 30, 66–89. [Google Scholar] [CrossRef] [PubMed]
- Brouwer, M.C.; Tunkel, A.R.; McKhann, G.M.; van de Beek, D. Brain Abscess. N. Engl. J. Med. 2014, 371, 447–456. [Google Scholar] [CrossRef] [PubMed]

| Antibiotic | MIC (µg/mL) |
|---|---|
| Ampicillin | ≤0.064 |
| Azithromycin | 0.094 |
| Ceftriaxone | 0.006 |
| Clindamycin | 0.004 |
| Imipenem | 0.125 |
| Meropenem | 0.125 |
| Penicillin G | 0.094 |
| Trimethoprim–Sulfamethoxazole | 0.003 |
| Reference | Years | Clinical Presentation | Sex | Ethnicity | Age (Years) | Immunity State | Underlying Conditions | Initial Symptoms/Signs | Outcomes | Treatment | Resistance (MIC) | Bacteria Isolated | Identification | Country |
|---|---|---|---|---|---|---|---|---|---|---|---|---|---|---|
| Emmerson and Mills [17] | 1978 | Meningitis and right cerebellar abscess | Female | Caucasian | 60-year-old | Immunocompetent | Several head and neck surgeries | Fever, generalized headache, anorexia, vomiting after meals, poor concentration, bizarre and erratic behavior and increasing drowsiness. | Died | Ampicillin 2 g/4 h IV for 10 days followed by oral amoxicillin 1 g/6 h and probenecid 500 mg b.d. for 1 week | No (disk diffusion) | E. corrodens, non-haemolytic streptococcus | Biochemical | UK |
| Zgheib A. et al. [18] | 1992 | Peritonsillar abscess and intrathoracic infection | Male | Caucasian | 52 | Immunocompetent | Oral antiseptic and surgical drainage of peritonsillar abscesses | Severe weakness, fever of 39.5 °C, dysphagia, mild retrosternal oppression | Survived | Erythromycin; Clindamycin in 400 mg IV 6-hourly; Gentamicin 5 mg/kg daily; Ticarcillin 5 g IV 6-hourly. | Clindamycin, amikacin (broth-dilution technique) | Eikenella corrodens | NA | Belgium |
| Dong and Gong [19] | 2013 | Chronic meningitis | Female | Asian | 50-year-old | Immunocompetent | Alcoholism, smoking | Pharyngodynia, fever, headache | Survived | Ampicillin/sulbactam (12 g/day) and 0.4 g/day IV levofloxacin | Ceftazidime | Eikenella corrodens | NA | China |
| Sawyer et al. [20] | 2015 | Early onset neonatal sepsis and associated meningitis | Male | Caucasian | 27-week | Immunosuppressed | Preterm labor | Respiratory distress, apnoea | Survived | ampicillin (100 mg/kg/dose every 12 h), gen- gentamicin (4.5 mg/kg/dose every 36 h), cefotaxime (50 mg/kg/dose every 12 h) | NA | Eikenella corrodens | NA | Texas |
| Yamagishi et al. [21] | 2018 | Lemierre’s syndrome | Male | Asian | 44 | Immunodepressed | IgG4-related ophthalmic disease | Dyspnoea, purpuric eruption | Survived | Meropenem; Clindamycin; Vancomycin; Ampicillin-Sulbactam; knee amputations | no | Gemella bergeri, Eikenella corrodens | ID Test HN-20 Rapidand16S rRNA gene sequencing | Japan |
Disclaimer/Publisher’s Note: The statements, opinions and data contained in all publications are solely those of the individual author(s) and contributor(s) and not of MDPI and/or the editor(s). MDPI and/or the editor(s) disclaim responsibility for any injury to people or property resulting from any ideas, methods, instructions or products referred to in the content. |
© 2025 by the authors. Licensee MDPI, Basel, Switzerland. This article is an open access article distributed under the terms and conditions of the Creative Commons Attribution (CC BY) license (https://creativecommons.org/licenses/by/4.0/).
Share and Cite
Cosio, T.; Mannavola, C.M.; Fiori, B.; Zelinotti, M.; Taccari, F.; Posteraro, B.; D'Inzeo, T.; Sanguinetti, M. Crossing the Barrier: Eikenella corrodens Bacteremia Following CNS Infection in a Patient Treated with Nivolumab—A Case Report and Literature Review. Microorganisms 2025, 13, 2135. https://doi.org/10.3390/microorganisms13092135
Cosio T, Mannavola CM, Fiori B, Zelinotti M, Taccari F, Posteraro B, D'Inzeo T, Sanguinetti M. Crossing the Barrier: Eikenella corrodens Bacteremia Following CNS Infection in a Patient Treated with Nivolumab—A Case Report and Literature Review. Microorganisms. 2025; 13(9):2135. https://doi.org/10.3390/microorganisms13092135
Chicago/Turabian StyleCosio, Terenzio, Cataldo Maria Mannavola, Barbara Fiori, Matteo Zelinotti, Francesco Taccari, Brunella Posteraro, Tiziana D'Inzeo, and Maurizio Sanguinetti. 2025. "Crossing the Barrier: Eikenella corrodens Bacteremia Following CNS Infection in a Patient Treated with Nivolumab—A Case Report and Literature Review" Microorganisms 13, no. 9: 2135. https://doi.org/10.3390/microorganisms13092135
APA StyleCosio, T., Mannavola, C. M., Fiori, B., Zelinotti, M., Taccari, F., Posteraro, B., D'Inzeo, T., & Sanguinetti, M. (2025). Crossing the Barrier: Eikenella corrodens Bacteremia Following CNS Infection in a Patient Treated with Nivolumab—A Case Report and Literature Review. Microorganisms, 13(9), 2135. https://doi.org/10.3390/microorganisms13092135

